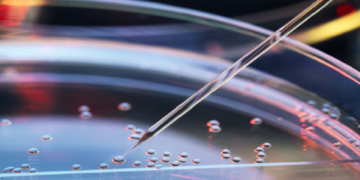
تجربة إنشاء “مزيج هجين” من خلايا البشر والقردة!

آخر تحديدث : الجمعة - 5: 06 :2026 / يونيو - 11:35:02 مساءً
بحوث ودراسات
تابعنا في فيسبوك
| ن | ث | أرب | خ | ج | س | د |
|---|---|---|---|---|---|---|
| 1 | 2 | 3 | 4 | 5 | 6 | 7 |
| 8 | 9 | 10 | 11 | 12 | 13 | 14 |
| 15 | 16 | 17 | 18 | 19 | 20 | 21 |
| 22 | 23 | 24 | 25 | 26 | 27 | 28 |
| 29 | 30 | |||||
آخر ما نشرنا
بيان دعم من اتحاد القبائل والأعيان في البلاد العربية للعراق العظيم
بسم الله الرحمن الرحيم نحن، اتحاد القبائل والأعيان في البلاد العربية، نؤكد تضامننا ودعمنا الكامل لحكومة وشعب العراق من شماله...
Read more